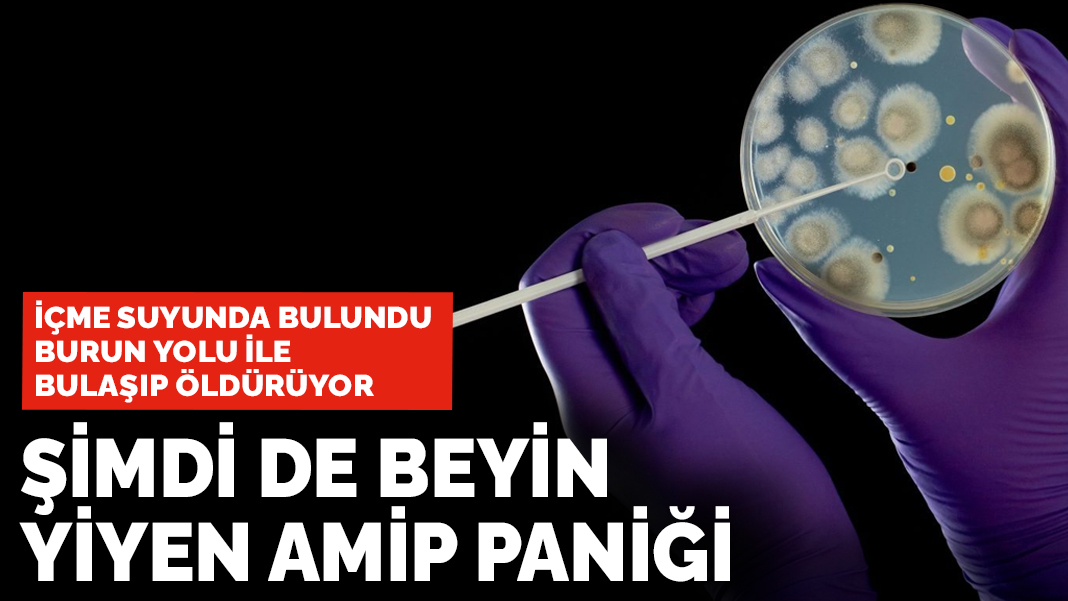
İçme suyunda bulundu: Beyin yiyen amip paniği

Et yiyen bakteri uyarısı yapan Güney Florida Üniversitesi bulaşıcı hastalıklar uzmanı Prof. Dr. Sandra Gompf, küresel ısınmaya dikkat çekti. Burun yolu ile bulaşan Naegleria fowleri baktarisinin çoğunlukla tatlı sularda bulunduğunu açıklayan bilim insanları zaman zaman ölümcül olabildiği vurguladılar.
KÜRESEL ISINMA TETİKLİYOR
Güney Florida Üniversitesi bulaşıcı hastalıklar uzmanı Prof. Dr. Sandra Gompf, “et yiyen bakteri” olarak da bilinen tuzlu su bakterisi Vibrio vulnificus ve tatlı sulardaki Naegleria fowleri gibi tehlikeli patojenlerin, küresel ısınma sonucunda ısınan suların etkisiyle artabileceği konusunda bilim insanlarının daha fazla endişelenmeye başladıklarına dikkat çekti.
Uzmanlar, kuvvetli sellerin tehlikeli patojenlerin üredikleri kirli suların taşınmasını kolaylaştırabileceğine işaret etti.
Öte yandan California Üniversitesi araştırmacısı Prof. Yun Shen, şiddetli kuraklık yaşanan bölgelerde bulunan su rezervlerinde yoğun olarak üreme potansiyeli bulunan patojenlerin, şehirlerin su şebekelerine karışma ihtimalinin de yüksek olduğunu ifade etti.
Son 10 yıldaki vaka sayısının tahmin edilenden daha fazla olduğunu belirten uzmanlar, küresel ısınma ile bu durumun daha da artabileceğini kaydetti.
Tuzlu sularda yaşadığı bilinen Vibrio vulnificus bakterisi ise ishal başta olmak üzere, kan dolaşımı enfeksiyonu ve kangren gibi sorunlara neden olabiliyor.

BURUN YOLU İLE BULAŞIYOR VE ÖLDÜRÜYOR
Beyinde enfeksiyona yol açan ve genellikle ölümcül olabilen, mikro ölçekli ve tek hücreli Naegleria fowleri burun yoluyla insan vücuduna giriyor.
Çoğunlukla göl, nehir, kanal gibi tatlı sularda bulunan amip, insandan insana geçmiyor.
Naegleria fowleri enfeksiyonları, sıklıkla ABD'nin güney eyaletlerinde görülüyor.
TATLI SULARDA BULUNUYOR
ABD Hastalıkları Kontrol ve Önleme Merkezine (CDC) göre, Naegleria fowleri enfeksiyonlarına nadiren rastlanıyor ancak ülke çapında 1962-2019 yılları arasında tespit edilen 198 vakadan sadece 4’ü kurtarılabildi.
Ülkede, 2009-2018 yıllarında tespit edilen 34 vakanın 30'u eğlence amaçlı girilen sulardan, 3'ü buruna çekilen kirli musluk suyundan ve biri de bahçeye kurulan bir su kaydırağında kullanılan kirli çeşme suyundan kaynaklandı.
 TÜRKİYE'DE DE GÖRÜLÜYOR
TÜRKİYE'DE DE GÖRÜLÜYOR
Türkiye'de de bazı amip türlerinin görüldüğünü belirten Hacettepe Üniversitesi Tıp Fakültesi Çocuk Enfeksiyon Hastalıkları Anabilim Dalı Başkanı Prof. Dr. Mehmet Ceyhan, "Güneydoğu'da görülen, bağırsakları etkileyen, bazen kana da geçip organları da etkileyen amip, bizde çok yaygın, özellikle yaz aylarında görülüyor. Ama dünyanın değişik bölgelerinde başka amipler de var. Bu amip de daha çok ABD'de görülen, uzun zamandır bilinen ve daha çok sudan insanlara buluşan bir amip. Beyin dokularını tutuyor, nadir vakalar şeklinde Amerika'da her sene görülüyor" dedi.
ESKİŞEHİR'DE GÖRÜLMÜŞTÜ
Prof. Dr. Ceyhan, 2017’de Eskişehir'de amip vakasının rapor edildiğini belirterek, "Veterinerlik fakültelerinin çalışmaları var. Birçok ili kapsayan sularda bu etkenlerin araştırıldığı çalışmalarda da rapor edilmiş. Yani Türkiye'de de var; ama çok sık görülen bir hastalık değil. Olduğu zaman genellikle beyin zarları ve beyin dokusunu tutan ama erken tanı konulduğunda tedavi edilebilen bir hastalık. Sulardan bulaşıyor, henüz insandan insana bulaştığı belirtilmemiş" dedi.